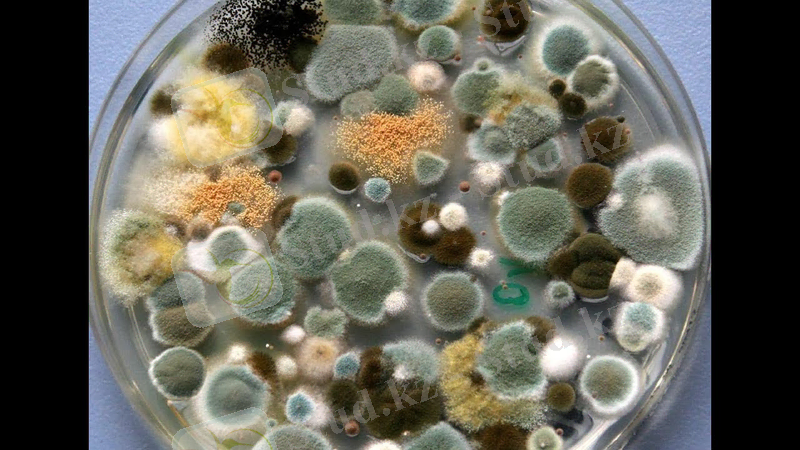
maxresdefault.jpg

Жануарлар мен құстардағы охратоксикоз: этиология, патогенез, клиника, диагностика және алдын алу


Жоспар:
I. Кіріспе
II. Негізгі бөлім
1. Охратоксиндер
2. Этиология
3. Патогенез
4. Клиникалық белгілері
5. Диагноз
6. Емі
III. Қорытынды
IV. Пайдаланылған әдебиеттер
I. Кіріспе
Ветеринариялық мамандар үшін өзекті мәселелердің бірі жануарлар мен құстарға арналған жемдерде болатын микроскопиялық саңырауқұлақтардың кейбір түрлерінің метаболиттерімен микотоксиндерден туындайтын аурулардың азаюын азайту болып табылады. Соңғы жылдары микотоксиндер мен микотоксикоздарды зерттеу бойынша елеулі зерттеулер жүргізілгеніне қарамастан, микотоксикоздардың патогенезімен байланысты көптеген мәселелер жеткіліксіз ашылмаған. Мал азығы мен өнімдеріндегі микотоксиндерді аналитикалық анықтау әдістерін өңдеуде шет елдерден әлі де айтарлықтай артта қалушылық байқалуда. Жануарлар мен құстың әр түрі үшін азықтардағы микотоксиндердің шекті рұқсат етілген мөлшерлерінің көрсеткіштері, метаболизмі, олардың ағзада шығарылуы және жиналуы жеткілікті дәрежеде толық зерттелмеген. Соңғы жылдары ашылған микотоксиндердің бірі охратоксиндер-Aspergillus және Peniclllium босану саңырауқұлақтарының кейбір түрлерінің метаболиттері болып табылады. Соңғы он жыл ішінде охратоксикоздар АҚШ, Канада, Дания, Швеция, Голландия, Франция, Италия, Польша, Югославия, Үндістан және басқа елдерде тіркелген, ал Украина мен Ресейде осы саладағы зерттеулер осы уақытқа дейін жүргізілген жоқ. Бірқатар зерттеушілер охратоксин-продуцентті саңырауқұлақтар орнатты, оларға жануарлар мен құстың әртүрлі түрінің сезімталдығын зерттеді.
Малдар ағзасына а охратоксин мөлшері мен А, В, С охратоксиндерінің қоспасының әсер ету динамикасында зерттеу болып табылады, алынған мәліметтер негізінде жануарлардың охратоксикоэдерін диагностикалау әдістерін әзірлеу және осы микотоксикоздың алдын алу бойынша ұсыныстар ұсыну. А охратоксинінің және А, В, С охратоксиндерінің қосындысының ішкі ағзалардың абсолюттік және салыстырмалы массалық көрсеткіштеріне әсерін зерттеу. Охратоксиндердің ағзаның кейбір иммунологиялық көрсеткіштеріне әсерін зерттеу. Жануарлар мен құстың охратоксикоздарымен күрес бойынша ұсыныстар әзірлеу.
II. Негізгі бөлім
... жалғасыМикотоксикоздар -өнімдер мен жем-шөпте болатын саңырауқұлақ токсиндерімен туғызылатын тірі ағзалардың улануы. Фузарий (Fusarium, қат. Hypomycetales) тұқымдасының саңырауқұлақ токсинімен уланған ұннан жасалған нанды пайдалану асептикалық ангинаны, балалардың сүйек қалыптасуының бұзылуын, лейкопенияны, аграгулоцитозды, т. б. туғызады. Қатты жем-шөпте мекендеп, стахиботрис (Stachybotris, қат. Hypomycetales) саңырауқұлағы даму үрдісінде улы заттар түзеді. Олар жануарларға (жылқы, қой, шашқа) түскенде күрделі улану туғызады. Мұнда оған тән ауыз, тамақтың кілегей қабаттарының некроздары, қан түзуші мүшелердің өзгеруі, сондай-ақ ішек-асқазан тракті жұмысының бұзылуы пайда болады. Мұндай жем-шөппен жұмыс істейтін адамдарда да ауру пайда болуы мүмкін. Аспергилл тұқымдасы саңырауқұлақтарының токсиндері паралич, парез, бауыр, үйрек және басқа да мүшелердің патологиялық өзгерістерін туғызады. Микотоксикоздар нашар жем-шөпте токсинді саңырауқұлақтарды табу арқылы анықталады, мұнда клиникалық және патологиялық белгілер еске алынады. Микотоксиндер-токсинді(улы) заттар, өнімі. Олар шартты екі топқа бөлінеді:бауыр мен бүйректі зақымдайтындар және басқа мүшелерді зақымдайтындар.
Микотоксикология -саңырауқұлақтармен бөлінетін улы заттар мен олар туғызатын ауруларды зерттейтін медицинаның саласы.
Охратоксикоз -микотоксикоз, бүйрек, бауыр зақымдалуына, өкпенің қабынуына әкеледі. Қоздырғыш - Aspergillus ocraceus.
Охратоксиндер -микотоксиндер, аспергилл туысының саңырауқұлақтарымен бөлінеді, өте қауіпті. Мицелий құрамынан қоректік субстратқа бөлінеді. Жем-шөпте, тағам өнімдерінде мекендеп, ол адам, жануар, құстардың улануына әкелуі мүмкін. Қауіптілігінің жоғарылығы саңырауқұлақтардың ұзақ уақыт сақталу, залалсыздандырудың түрлі әдістеріне төзімділік пен ағзада жиналу қабілеттілігінде. Бұл микотоксиндердің тератогенді және канцерогенді әсері байқалған. .
Негізінен бұл ауру кезінде бүйрек пен бауыр зақымданады, бұл оны нсфропатия деп атауға негіз болды (Th. Kin, 1895) . Алайда, қоректенетін мал азығы мен зақымдалған бүйрек арасындағы байланыс алғаш рет s. Laisen (1928) сойылған шошқаларға зерттеу жүргізді.
Және 1965 ж. д. Скотт a. ochraceus саңырауқұлағы дақылынан таза түрде микотоксин охратоксин бөліп алды. Бұл басқа ғалымдардың назарын аударды, содан кейін охратоксикозды жаппай зерттеу басталды. Охратоксин жануарлар ағзасына ауру тудыратын әсердің алуан түрлілігі тек мал шаруашылығы үшін ғана емес, сонымен қатар адам үшін де қауіпті. Олар сут құрамында сүт өнімдерде және сойылатын жануарлардың етінде болуы мүмкін.
Көптеген охратоксиндер түрлері кездеседі олар: охратоксин А (дигидроизокумарин, өзінің 7-карбогруппасымен "А", " В"-фенилаланинмен байланысты), охратоксин В (дихлораналог), охратоксин С және D, тиісінше этил және метил эфирі охратоксин А. Барлық охратоксиндер арасындағы ең улылығы ол А охратоксин. Ол хлороформада, бензолда, ацетонда, спиртте, су бетінде еритін түссіз кристалды зат болып табылады.Охратоксин А қышқыл микотоксиндер тобына жатады, оны азықта анықтаған кезде ескеру қажет (А охратоксинді рН қышқылында азықтан экстрагациялайды. Ыдыстың қабырғаларындағы сілтінің қалдықтары оларға А охратоксинінің шөгуіне және талдаудың қате нәтижелеріне әкеп соғады) .
Иттер мен шошқалардың охратоксиндеріне ең сезімтал. Охратоксиндер бидай, арпа, сұлы, жүгері дәндерінде, бұршақ тұқымдарында, жер жаңғақтарында, құрама жемде анықталаған. Охратоксин А ыстыққа қабілетті. 3 сағат ішінде автоклавталған сұлы мен күріш әлі де оған енгізілген охратоксиннің 30%-ын құрайды.
Охратоксиннің иммуносупрессивті әсері келесі жолмен жүреді. Алдымен бұл токсин митохондрияда тотығу стрессін тудырады, еркін радикалдардың түзілуін арттырады және антиоксиданттық жүйенің тиімділігін төмендетеді. Бұл үдерістер иммундық жасушалар рецепторларының тотығу зақымдануына алып келеді, әртүрлі иммундық жасушалар арасындағы коммуникацияны бұзады. Нәтижесінде дененің иммундық компетенттілігі төмендейді.
Микотоксиндердің иммуносупрессивті әсері экономикалық салдарлар тұрғысынан а охратоксинінің құсқа әсері ең қауіпті ретінде қарастырылады. Сондай-ақ, құстарда вирусты және бактериялық ауруларға сезімталдық артады, бұл өз кезегінде оның сақталуын төмендетеді.
Охратоксиндердің макромолекул синтезіне әсерін зерттеу нәтижелері охратоксин А ақуыз және РНК синтезін тежейді, бірақ ДНК синтезіне әсер етпейді. А охратоксиннің әсер етуінің молекулалық механизмдерінің негізінде ақуыз биосинтезіне фенилаланинацил-тРНК концентрациясының таңдамалы азаюы және полиспен өмір сүру кезеңінің артуы жатады. ішінара тазартылған препараттармен эксперименттерде охратоксин ферменттің белсенділігін бәсеңдететін бәсекелес тежегіш ретінде өзін жүргізді. Осындай әсерге ие (4R) -4-гидроксиохратоксин А - ішінара охратоксин гидролизінің өнімі.
А. охратоксин уыттылығының молекулалық механизмдері.
А охратоксиннің уытты әсерінің ең маңызды молекулалық механизмдері болып табылады:тотығу стресс және липидтердің, ақуыздардың және ДНҚ тотығуын қоса алғанда, оның салдары; а-ДНК-кешендерінің охратоксин түзілуі және маңызды гендердің экспрессиясының өзгеруі; митохондрий функциясының бұзылуы және еркін радикалдардың пайда болуын арттыру және витагендердің экспрессиясын тежеу есебінен антиоксиданттық жүйені ыдырату; фенилаланин алмасуының және ақуыз синтезінің бұзылуы а охратоксинні иммуносупрессивті әсері.

Этиология . Охратоксиндердің ең типтік продуценті, онда оның атауы Aspergillus ochraceus саңырауқұлағы болып табылады. Алайда, оларды Penicillium viridicatum, P. variable, P. cyclopium, P. commune, p. purpurescens, A. sulphureus, A. alliaceus, A, sclerotiorum және т. б. саңырауқұлақтар өндіре алады.
A. ochraceus саңырауқұлағы ауаның салыстырмалы ылғалдылығы 78-80% және одан жоғары немесе астықтың дәл осындай ылғалдылығы кезінде сақталатын астықта дамиды. Дәнді дақылдар үшін 15-15, 5%. Алайда Penicillium тектес саңырауқұлақтар 12-25° С температурада охратоксиндерді үрлеуі мүмкін.
Токсиндерді үрлеуге әсер ететін тағы бір маңызды фактор қоршаған ортадағы оттегі мен көмірқышқыл газының шоғырлануы болып табылады. Мысалы, ортадағы оттегінің концентрациясы 40% - ға ұлғайған кезде А охратоксин синтезі 75% - ға басылды, ал СО2 концентрациясы 30% - дан астам жоғарылаған кезде оттегінің мөлшеріне қарамастан токсиндер өнімі толық тоқтатылды.
Табиғи жағдайларда маңызды фактор субстратта басқа токсикогенді микроскопиялық саңырауқұлақтардың болуы болып табылады. Мысалы, а. ochraceus және Р. granulatum(патулиннің продуценті) бірге өсіру кезінде охратоксин а синтезі күрт төмендеді. А. ерекшеліктері.
Охратоксин А - ішектің жұқа бөлігінде, ең жоғары-оның жоғарғы бөлігінде иондалмаған нысанда сіңірілетін май еритін зат. Бұл микотоксиннің ішекте сіңуі концентрация градиентіне қарсы жүреді және ішектің шырышты рН байланысты. Оның сіңу қарқындылығы көптеген факторларға байланысты, бірақ орташа алғанда ол балапандарда шамамен 40%, торайларда 66%, егеуқұйрықтар мен қояндарда 56% құрайды. Охратоксин а қанға түсіп, сарысулық альбуминмен және басқа да макромолекулалармен оңай байланысады. Осы микотоксинді бір рет қабылдағаннан кейін оның қан сарысуында ең жоғары концентрациясы анықталды:балапандарда - 0, 33 сағаттан кейін, қояндарда 1сағаттан кейін, торайларда 10-48 сағаттан кейін, бұзауларда - 2-4 сағаттан кейін.
Патогенез. Охратоксиндер негізінен бүйрек және бауыр жасушаларына әсер етеді. Бүйрек канальцияларының, мальпигиялық түйнектердің, сондай-ақ бауыр перипорталдық жасушаларының эпителийінің некрозы дамиды. Охратоксиндер эмбриотоксикалық әсерге ие. Охратоксикоздың эксперименталды түрде қанға Жануарлар охратоксиндерін енгізу жолымен көбеюі майлы инфильтрацияға, гиалинді регенерацияға және бүйрек пен бауыр некрозына алып келеді. А, в. С охратоксиндерінің қоспасын енгізген кезде ауру қанға түскен улардың санына байланысты жіті, өткір және созылмалы түрлерде ағады.
Клиникалық белгілері. Шошқада охратоксикоздың жіті түрі күн сайын 6 тәулік бойы 1 мг охратоксин А 1 кг мал массасына дамиды. Жануарлардың тәбеті жоғалады, депрессия, диарея, дене қызуының 1-2° С-қа көтерілуі, полидипсия, полиурия, ағзаның сусыздануы, прострация, содан кейін қайтыс болады. Анамнездің жедел формасындағы ократоксикоздың клиникалық көрінісі жануарлардың тамақтанудан бас тартуымен, полиуриямен, жалпы депрессиямен, терініңісінуімен, ентігумен, диареямен, сондай-ақ кхормен ауысатын диареямен, бел аймағындағы пальпациямен перинефральды ісінудің салдарынан ауырады. Шошқалардың дене температурасы қалыпты. Ауру малдардың 50-ден 90% - ға дейін өлген.
Охратоксикоздың созылмалы түрі шошқада құрамында 1 кг Жемге 0, 1-ден 0, 4 мг-ға дейін охратоксин А бар керма қоректендіргенде дамиды. Токсикоздың бұл түрі микотоксикалық нефропатия деп аталатын аралас микотоксикоз түрінде жиі өтеді.
Супорос шошқаларында аборттар, өлі немесе өмір сүруге қабілетсіз ұрпақтардың пайда болуы мүмкін. Эмбриондардың өлуіне және кейін сорылуына байланысты қайталама ұрықтандырулар саны артады. Жас супорос шошқалары ескі немесе бордақылаудағы жануарларға қарағанда ауруға сезімтал.

Патологоанатомиялық өзгерістер . Асқазанның шырышты қабығы және ішектің жұқа бөлігі катаральды қабыну. Бауыр көрінбейтін макроскопиялық өзгерістерсіз біркелкі боялған. Бүйрек аздап өсті. Капсула кей жерлерде қабықпен жабыстырылған. Қабық және ми қабаттарында шектеулі немесе диффузды неғұрлым ашық учаскелер бар. Кейбір жағдайларда бұл учаскелер тығыздалуы мүмкін. Гистоморфологиялық зерттеумен жедел нефроз, липоидты нефроз, ісіну, шектеулі интерстициальді нефрит, фиброзды интерстициальді нефрит белгіленеді.
Диагноз. Охратоксикозға диагноз қою кезінде аурудың инфекциялық табиғатын, сынап органикалық қосындылармен, басқа микотоксиндермен (рубратоксиндермен, стеригматоцистинмен, цитринмен, пеницилл қышқылымен) улануды болдырмайды.
Диагноз аурудың клиникалық белгілері, патологоанатомиялық өзгерістер, сондай-ақ афлатоксикозға диагноз қою кезіндегі схема бойынша жүргізілген микотоксикологиялық зерттеулердің нәтижелері негізінде қойылады.
Емі. Охратоксикоз кезінде арнайы ем әзірленбеген. Мал рационынан уыттылық сезікті азықты алып тастайды. Ауру жануарларға метионин, цистин (антидот ретінде), сондай-ақ Е витамині немесе жасыл масса тағайындайды. Ауыл шаруашылығында және құс шаруашылығында охратоксиндермен күресу әдістері.
Соңғы жылдары құс шаруашылығы мен мал шаруашылығында микотоксикоздардың, оның ішінде охратоксикоздың алдын алуда айтарлықтай ілгерілеуге қол жеткізілді.
Охратоксиндердің көзі контаминирленген астық болып табылады. Астық өндірушілер оңтайлы температура мен ылғалдылыққа төтеп бере отырып, оны сақтау шарттарына көп көңіл бөле бастады, бұл зең саңырауқұлақтарының дамуын және микотоксиндердің зақымдануын айтарлықтай төмендетті. Жемдегі микотоксиндерді анықтау үшін аналитикалық база айтарлықтай жақсарды, бұл кіріс шикізатқа тиімді бақылау жүргізуге және ет пен жұмыртқа өндіру кезінде микотоксикоздардың пайда болуын төмендетуге мүмкіндік берді. (МЕМСТ 32587-2013 астық және оны қайта өңдеу өнімдері, құрама жем.
Жоғары тиімді сұйық хроматография әдісімен а охратоксинді анықтау) . Шикізатты мұқият бақылауға қарамастан, охратоксиннің азыққа түсуін болдырмау өте қиын және бұл проблеманы шешу әлі толық мүмкін емес. Нәтижесінде бұл микотоксин тамақ тізбегіне сөзсіз түседі: құрама жем > құс > адам.
Охратоксин А - жеткілікті тұрақты қосылыс және азық сапасын жоғалтпай, оның температуралық немесе химиялық өңдеуімен жою немесе жою мүмкін емес екені дәлелденді. Сондықтан бұл микотоксинді адсорбенттерді пайдалану арқылы құс ағзасынан шығару идеясы ұсынылды. Азықтық нарықта мұндай адсорбенттердің үлкен ассортименті бар, алайда олардың ешқайсысы құстың АІЖ бойынша азықтың тез жылжуына байланысты, сондай-ақ ылғалдылықты, температураны, бөлшектер мөлшерін және т. б. қоса алғанда, көптеген басқа факторларға байланысты охратоксинді немесе басқа да микоуыттарды 100% байлауға және ағзадан шығаруға қабілетсіз. Жүргізілген талдаулар адсорбенттерді пайдаланудың орынсыздығын көрсетті. Охратоксикоз кезінде құстар сорбентті азыққа енгізгенге дейін оған түсіп үлгерген микотоксиндермен күресу үшін бауыр мен бүкіл ағзаның жұмысын қолдау қажет. Бұл охратоксин а өз детоксикация жүйесін бұзады ескере отырып, әсіресе маңызды. Сорбенттер микотоксиндерді байланыстырумен қатар, спецификалық емес байланыстырушы белсенділікке ие бола отырып, витаминдер мен минералды заттарды адсорбциялайды, бұл құс ағзасындағы тепе-теңдікке әкеледі. Яғни бір мәселе шешіледі, ал екіншісі құрылады.
Микотоксиндер әсерінің биохимиялық механизмдерін түсіну саласындағы молекулалық биологияның жетістіктері, витагендер концепциясын әзірлеу және нутригеномика деректері микотоксикоздармен күресте жаңа шешімдерді ұсынуға мүмкіндік берді, атап айтқанда осы мақсат үшін жаңа стресске қарсы препараттарды пайдалануға мүмкіндік берді. Жоғарыда айтылғандай, охратоксиндердің негізгі әсер ету
- Іс жүргізу
- Автоматтандыру, Техника
- Алғашқы әскери дайындық
- Астрономия
- Ауыл шаруашылығы
- Банк ісі
- Бизнесті бағалау
- Биология
- Бухгалтерлік іс
- Валеология
- Ветеринария
- География
- Геология, Геофизика, Геодезия
- Дін
- Ет, сүт, шарап өнімдері
- Жалпы тарих
- Жер кадастрі, Жылжымайтын мүлік
- Журналистика
- Информатика
- Кеден ісі
- Маркетинг
- Математика, Геометрия
- Медицина
- Мемлекеттік басқару
- Менеджмент
- Мұнай, Газ
- Мұрағат ісі
- Мәдениеттану
- ОБЖ (Основы безопасности жизнедеятельности)
- Педагогика
- Полиграфия
- Психология
- Салық
- Саясаттану
- Сақтандыру
- Сертификаттау, стандарттау
- Социология, Демография
- Спорт
- Статистика
- Тілтану, Филология
- Тарихи тұлғалар
- Тау-кен ісі
- Транспорт
- Туризм
- Физика
- Философия
- Халықаралық қатынастар
- Химия
- Экология, Қоршаған ортаны қорғау
- Экономика
- Экономикалық география
- Электротехника
- Қазақстан тарихы
- Қаржы
- Құрылыс
- Құқық, Криминалистика
- Әдебиет
- Өнер, музыка
- Өнеркәсіп, Өндіріс
Қазақ тілінде жазылған рефераттар, курстық жұмыстар, дипломдық жұмыстар бойынша біздің қор #1 болып табылады.



Ақпарат
Қосымша
Email: info@stud.kz